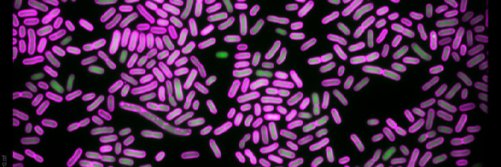
Infection Inspection banner

Infection Inspection retweetledi

Researchers from @OxfordPhysics and @NDMOxford are collaborating on a new diagnostic test for bacterial infections and #AntimicrobialResistance. We've created a short film about the test and its #CitizenScience project @InfectInspect.
Read more here 👇 oxfordmartin.ox.ac.uk/long-read/comb…
English